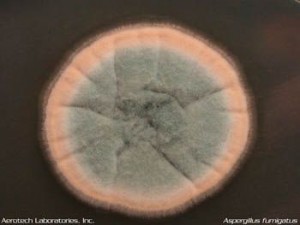
Aspergillus fumigatus mold in petri dish. A fumigatus sometimes causes fungal infections in the lungs. <yoastmark class=

A Accredited Mold Inspection Service, Inc.
Established 2003.
Experience With and Information on Fungal Infections in the Lungs from Our Certified Mold Inspector
When calling our office, people sometimes tell us they have a fungal infection so their doctor told them to have home mold testing conducted. Fortunately, fungal infections are very rare, but it happens. One of the worst types of fungal infections is a fungal infection in the lungs or Aspergillosis. Imagen mold growing in your lungs, in addition, imagine being allergic to that same mold. It is a horrible condition and I have encountered a few clients who went through this very scenario.
However, it is much more common for our inspector to do home mold testing because a doctor found mycotoxins in a client’s blood. We do this types of mold testing quite regularly. Serious fungal infections are rare but can be deadly.
Besides the below article on mold growth in human lungs, our mold inspector also provide inspections and testing in homes all over South East Florida. In addition to being licensed, our local inspector Daryl Watters is a CIEC or Certified Indoor Environmental Consultant. This is by far one of the most respected certifications in the industry. He has decades of mold inspection experience. He has provided many mold inspection in Palm Beach, Dade, and Broward Counties.
Fungal Infection in The Lungs
The most common type of mold encountered by certified mold inspectors are Penicillium and Aspergillus. For individuals with allergies who are otherwise healthy, these molds frequently trigger allergic responses. In people with weakened immune systems, Aspergillus molds can occasionally cause infections, including rare lung infections.
Aspergillosis Information
According to various scientific studies and this mold investigator’s personal experience, Aspergillus species are by far the most common molds found in water damaged homes. It is very often green or sometimes brown, or black, and it is common to find white varieties growing on clothes and furniture in humid homes.
Furthermore, if you have cancer and are undergoing chemotherapy, or are taking high doses of steroid medications you may be more likely to develop Aspergillosis. In addition, if you have lungs damaged by previous TB infections, or have a weakened immune system, you may be more likely to develop Aspergillosis.
Aspergillosis is the noninvasive growth of Aspergillus fungus balls in the lungs. These fungus balls are about 1/8 to 1 inch or so in size and are round or shaped as a half-moon. Sometimes, an infected person will cough one up since they are usually loose or will have allergic reactions to the mold in the lungs.
The condition can be very serious and should be diagnosed by a doctor usually via biopsy or X-rays. Treatment may involve various antibiotics. In 2004, I conducted a certified mold inspection on a property in West Palm Beach, Florida where the tenant had Aspergillus Niger growing in her lungs. In the same year, I did a mold inspection on a doctor’s moldy condo unit in Ft Lauderdale Florida. One of the doctor’s patients, had a serious and rare case of Aspergillosis.
The mold began to invade, growing not only freely inside the lungs but also extending deep into lung tissue and other areas of the body.
The three most common causes of this condition are Aspergillus fumigatus, Aspergillus flavus, and Aspergillus niger. Although all three are frequently found during home mold testing, it is rare for them to lead to infections.
Aspergillus conidiophore under a microscope. Certain types of Aspergillus can lead to lung infections caused by fungi.
Aspergillus fumigatus mold in petri dish. A fumigatus sometimes causes fungal infections in the lungs.
Aspergillus fumigatus
Aw 0.82; Optimum 0.97. Conidia dimensions 2-3.5 microns. This is the major cause of Aspergillosis. This organism is responsible for causing both invasive and allergic forms of Aspergillosis. Aspergillosis affects individuals who are immune compromised. This organism thrives at 35°C and is often discovered outside in compost heaps where temperatures exceed 40°C, as well as in moderately warm soils and on grains.
Aspergillus flavus
Aw 0.78.Conidia dimensions 3-6 microns or 3-5 microns. It grows on moldy corn and peanuts. This can be located in warm soil, as well as in food items and dairy products. Certain strains produce aflatoxins, a type of mycotoxin. Aflatoxins are known as an animal carcinogen or cancer causing agent. There is limited evidence to suggest that this toxin is a human carcinogen causing liver cancer when consumed.
The toxin is poisonous to humans by ingestion. Furthermore, it may also result in occupational disease via inhalation. Experiments have indicated that it is teratogenic and mutagenic. It is toxic to the live and reported to be allergenic. Reports have linked its presence to asthma, and it is often discovered in carpets that have sustained water damage. The production of the fungal toxin is dependent on the growth conditions and on the substrate used as a food source. This fungus is associated with aspergillosis of the lungs and/or disseminated aspergillosis. Also, this fungus is occasionally identified as the cause of corneal otomycosis and nasal orbital infections.
Aspergillus niger
Aw 0.77; Optimum 0.97. Conidia dimension 3.5 – 5 microns or 4 to 5 microns. This is a less common cause of aspergillosis. It commonly grows on water damaged walls and baseboards. This mold has been reported to cause skin and pulmonary infections. In addition, it is a common cause of fungi-related ear infections-otomycosis. This is one of the most common Aspergillus species encountered by this certified mold inspector in severely water damaged buildings. To the eye, it often resembles Stachybotrys when growing in water damaged buildings. The spores look like sea urchin shells without the spines.
__________________________________________________________________________________________________________________________________________________________________________________________________________________________________________________________
About At A Accredited Mold Inspection Service, Inc.
Our assessor and indoor air quality testing specialist provides home mold testing and inspections for:
Homeowners, renters, commercial and residential building managers. In addition, depending on what you request, and what you pay for, we can provide home mold testing and inspections, chemical AKA indoor air quality issues testing, or musty odors investgations. in addition, we also can provide allergens, and moisture or humidity problem inspections. We provide services for all towns in, near, and around South East Florida.




